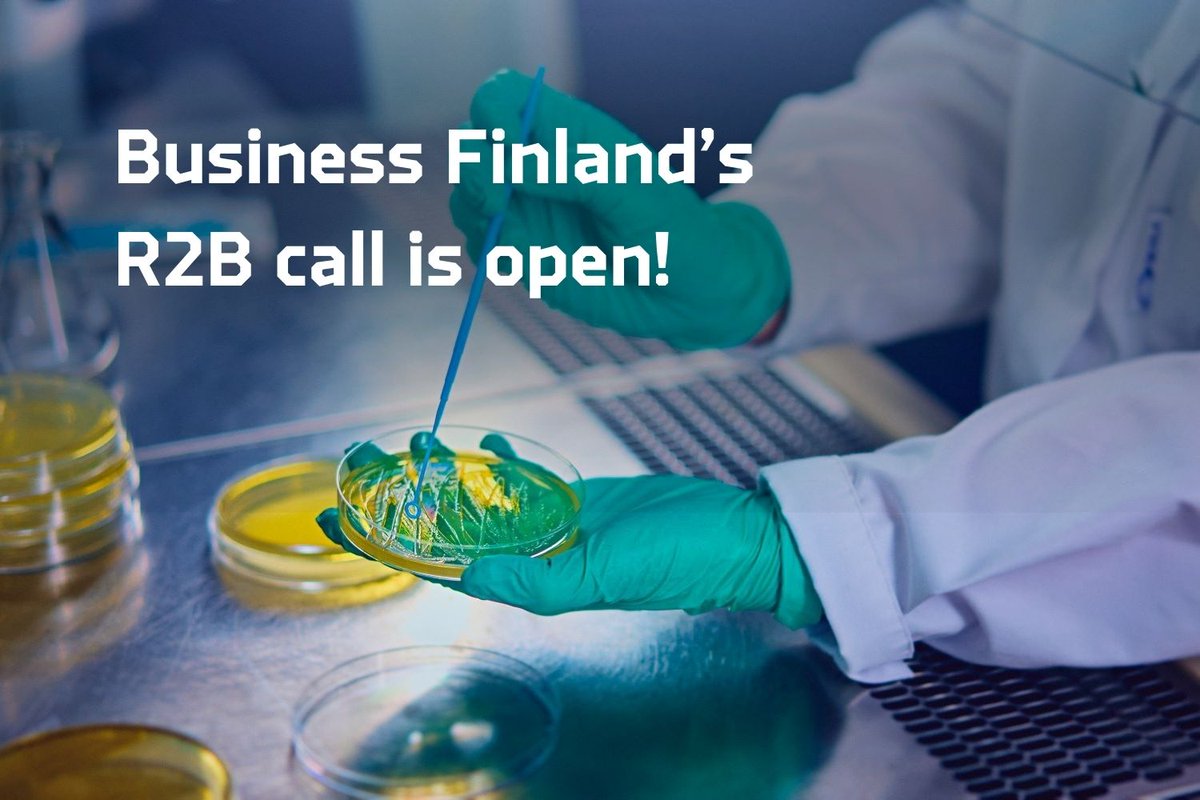
#BusinessFinland's #R2B call is open!

The application deadline is on March 5, 2025.
⚠️ The Spring call includes some updates to take note of. There will be an info session in January to go through them. Stay tuned!

Learn more on BF website. ➡️ businessfinland.fi/en/whats-new/c… #UICOulu

Oulu University Innovation Centre
@uicoulu
A service of University of Oulu (@UniOulu) that aids businesses in utilising research. #uicoulu #research2business #research4business #Oulu
ID: 1273575543779274752
https://www.innoblogi.com/ 18-06-2020 11:17:40
957 Tweet
778 Takipçi
754 Takip Edilen












#OIA-Olkkarissa tehtiin kurkistus Ouluversumiin. Se on oululainen #metaversumi, joka yhdistää virtuaalisen ja todellisen maailman teknologioita. Tämä ekosysteemi tukee teknologiaosaamista ja kehittää uusia tuotteita ja palveluita. University of Oulu on mukana kehitystyössä. #UICOulu


Attention #researchers: it’s your time to shine! On Jan 13, 2025, Business Finland launches the Rise to Challenge #funding call, seeking breakthrough ideas to revolutionize markets. ⏳ Applications close on Mar 31, 2025 💬 Info session: Jan 21 More info: businessfinland.fi/en/whats-new/n…







Ompeletko vaatteita Marimekon kankaista? Neulotko sukkia, joita koristavat logot, kuten Unikko, Karhu tai Pätkis?🧶Monia tuttuja kuoseja ja logoja suojaavat #immateriaalioikeudet. Milloin tarvitset niiden käyttämiseen luvan? Lue blogista: innoblogi.com/blogi/kasitoid… #IPR Maarit Jokela